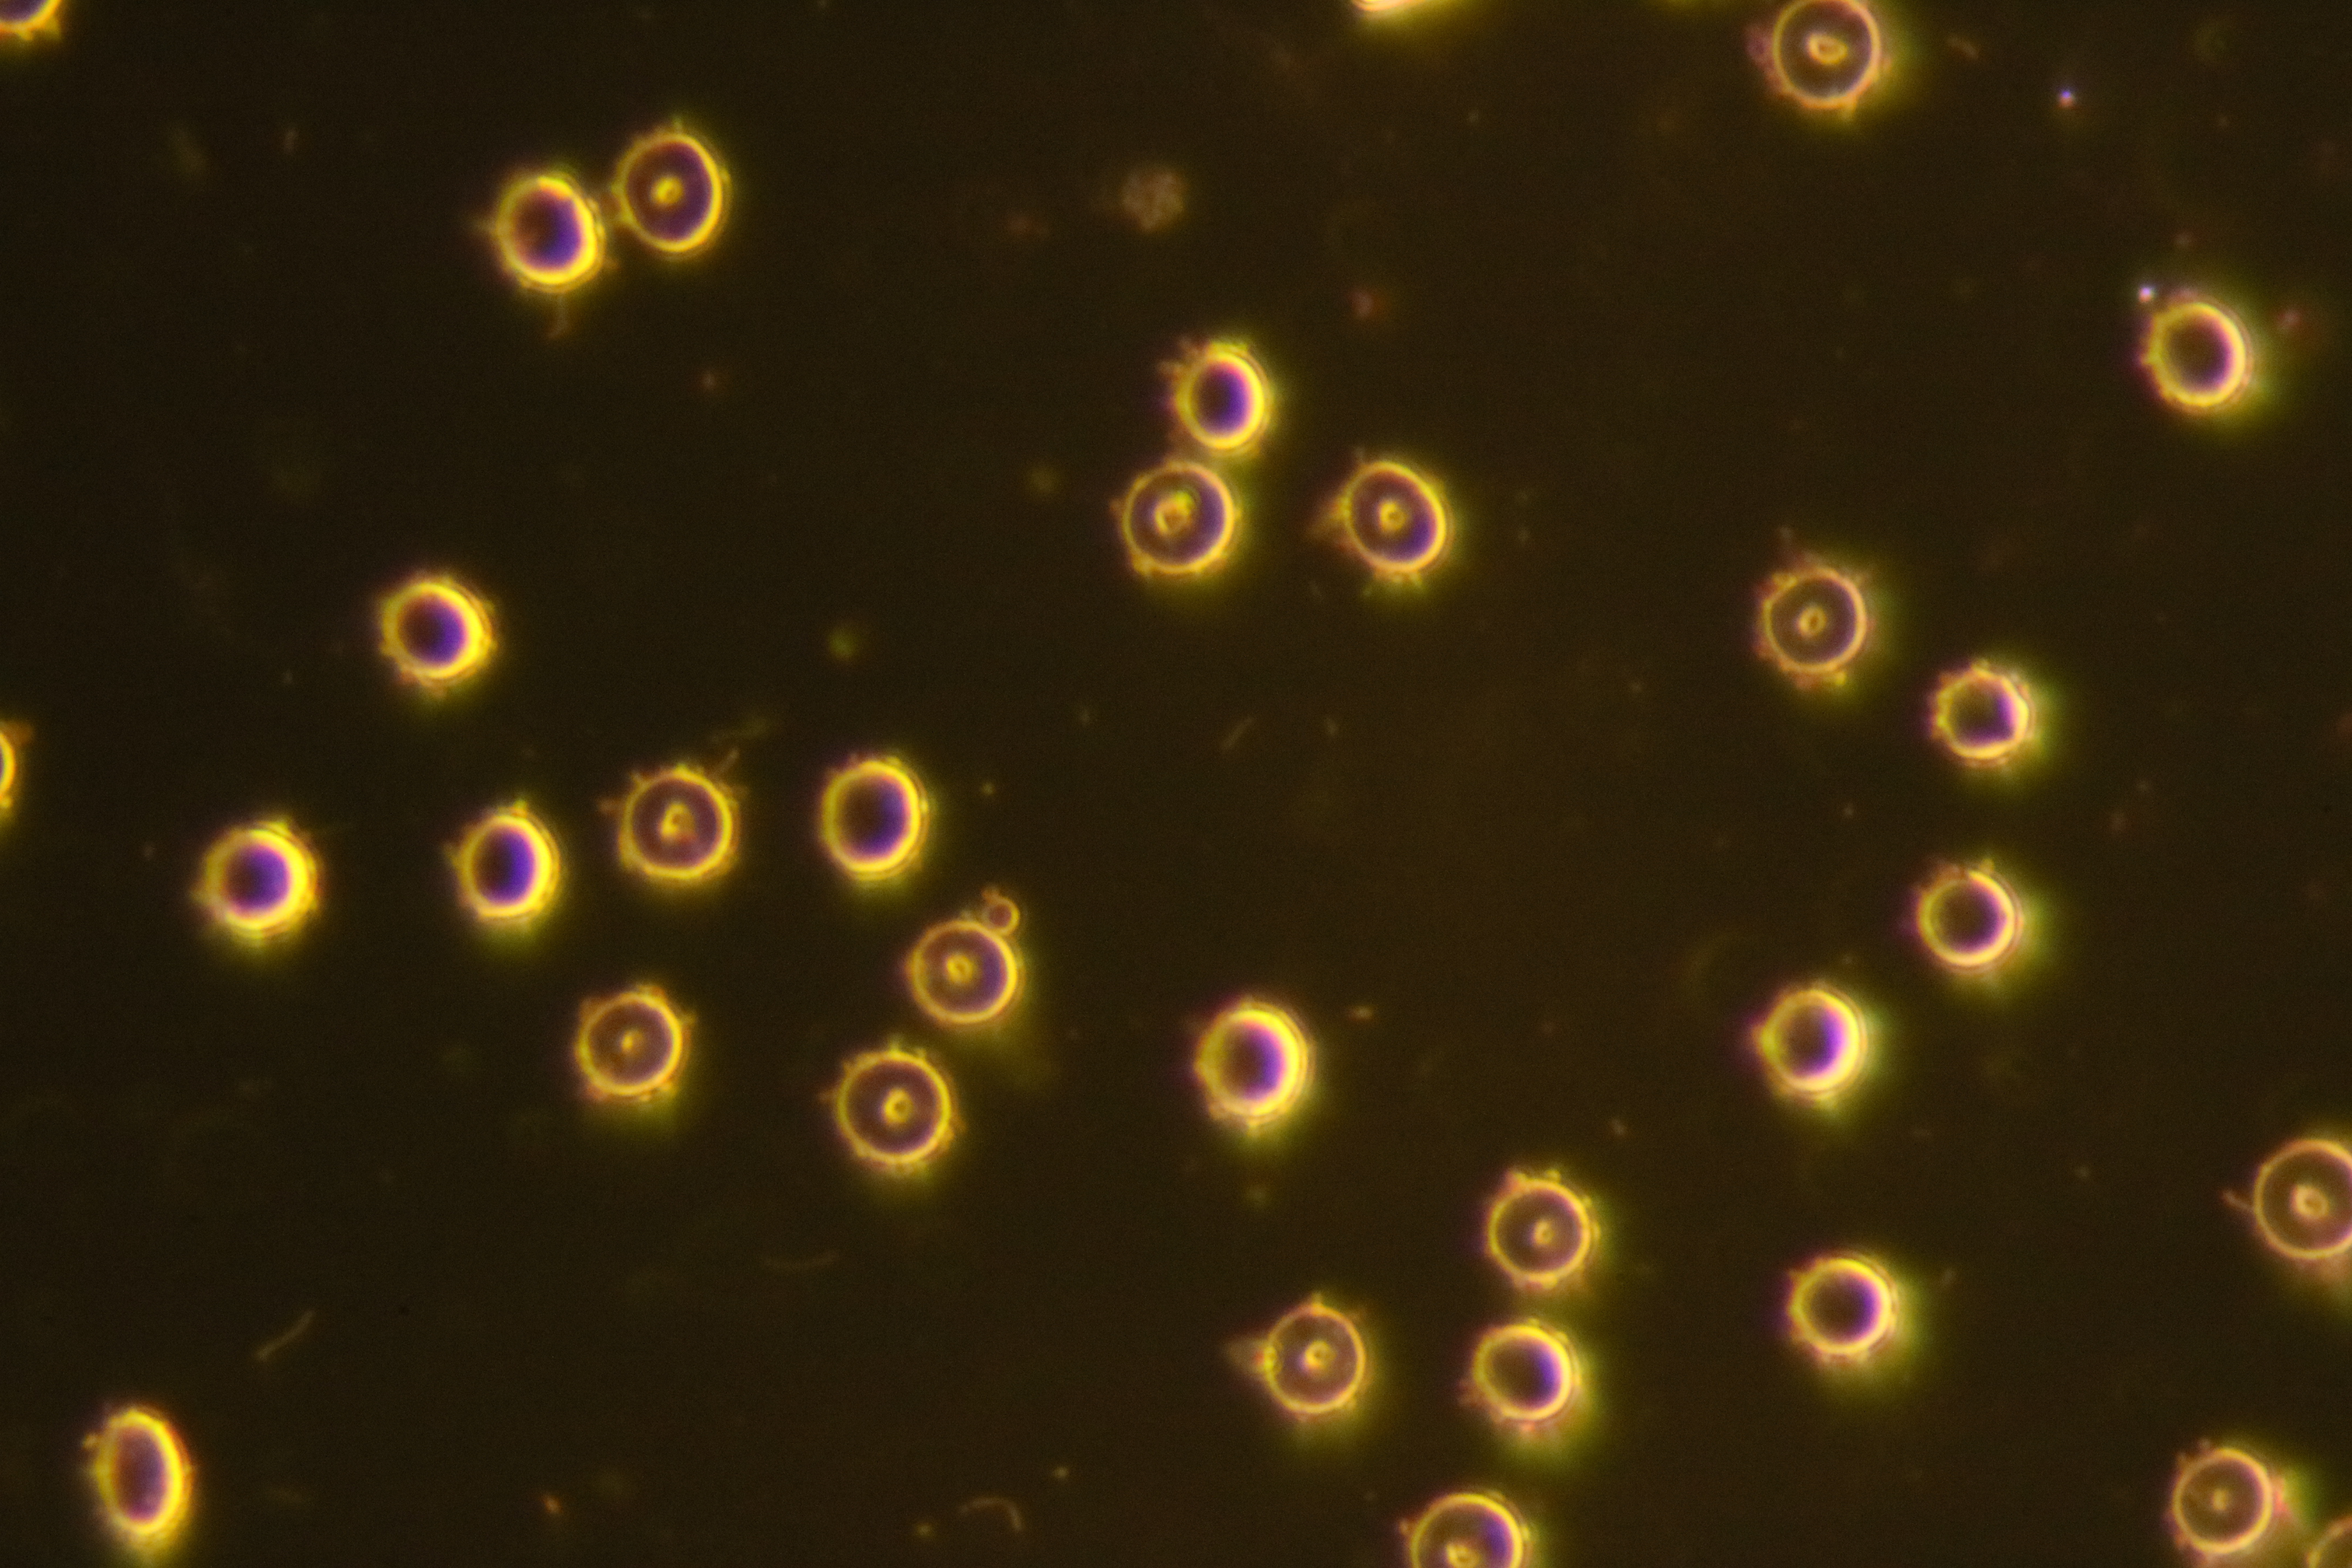

– IN SEARCH OF ANSWERS–
INTRODUCTION
Korean Red Chicken
Additional sentence can be added here for additional supporting details about image or other information.
Italian Salad
Additional sentence can be added here for additional supporting details about image or other information.
Pasta Snack
Additional sentence can be added here for additional supporting details about image or other information.
Bread Mutton
Additional sentence can be added here for additional supporting details about image or other information.
Palak Paneer
Additional sentence can be added here for additional supporting details about image or other information.
Chop Meat
Additional sentence can be added here for additional supporting details about image or other information.
Indian Salad
Additional sentence can be added here for additional supporting details about image or other information.
– Alleged Borrelia or other Spirochetes –
typical pictures
Blood slide with a ‘serious infection’ of borrelia!
Luckily for the blood donor, this is nothing of the sort. The alleged spirochetes, emerging from the red blood cells (RBCs) are not spirochetes at all. They are ‘accidentally produced’ by the slide making process. Darkfield microscopy when used on live blood is very prone to produce these things. And many inadequately trained or inexperinced operators assure their customers, that they have now been diagnosed with borrelia … The good news is … these are NOT borrelia or any other spirochete.
We Created best dinning experience for you & your family
Nanon elit libero. Quisque massa porta ut placerat lentesque non diam. Nam convallis porta rhoncus. Maecenas varius eget turpis suscipit porta sapien tinc Mauris tempor libero fringilla orci vivrra faucibue fringilla orci vivrra faucibus. Integer ullamcorper erat in tellus efficitur, quis porta sapien tincidunt. Nunc mattis lectus sed semper semper.
Donec viverra vel massa at posuere. Aliquam et fringilla augue consequat posuere sem, eu ornares viverra veleso massa at posuere. Aliquam et fringilla augue




– Now Booking –
Private Dinners & Happy Hours
– Dicover –
Our Special Menus
Veg Salad
Praesent pulvinar neque pellentesque mattis pretium
Dryfruits Veg.
Praesent pulvinar neque pellentesque mattis pretium
Desert Combo
Praesent pulvinar neque pellentesque mattis pretium
Maggie Noodels
Praesent pulvinar neque pellentesque mattis pretium
Butter Chicken
Praesent pulvinar neque pellentesque mattis pretium
Veg. Omelette
Praesent pulvinar neque pellentesque mattis pretium
– Testimonial –
What People Say
John Phillipe
A British classic
Sed ut perspiciatis unde omnis iste natus error sit voluptatem accusantium doloremque laudantium, totam rem aperiam, eaque ipsa quae ab illo inventore veritatis et quasi beatae.
Samantha Greenberg
A British classic
Sed ut perspiciatis unde omnis iste natus error sit voluptatem accusantium doloremque laudantium, totam rem aperiam, eaque ipsa quae ab illo inventore veritatis et quasi beatae.
Marco Williams
A British classic
Sed ut perspiciatis unde omnis iste natus error sit voluptatem accusantium doloremque laudantium, totam rem aperiam, eaque ipsa quae ab illo inventore veritatis et quasi beatae.










